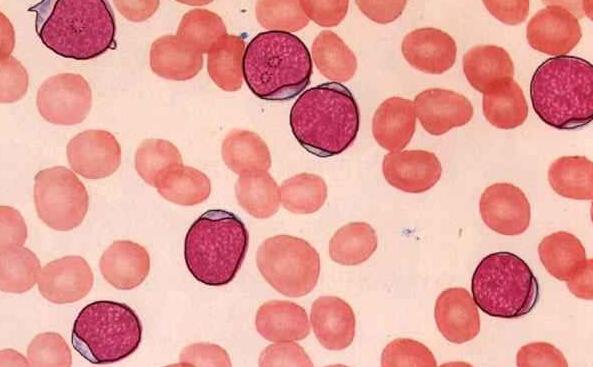
白血病细胞浸润

白血病细胞图片

白血病细胞
图片尺寸451x339
体检中心健康体检发现急性早幼粒细胞白血病一例
图片尺寸1600x1200
白血病细胞
图片尺寸400x300
转:中国爷爷用蜡烛木板战胜最凶险急性杀人白血病!
图片尺寸608x423这是慢性淋巴细胞白血病
图片尺寸1080x1439
白血病细胞浸润
图片尺寸593x367
白血病,细胞,人老心不老,显微镜,健康保健图片素材_id:350176572
图片尺寸612x601原发性浆细胞白血病一例分享_医学界-助力医生临床决策和职业成长
图片尺寸805x537
外周血涂片#淋巴细胞白血病
图片尺寸644x1082
急性淋巴细胞白血病l3图谱
图片尺寸1152x864
漫漫诊断路——慢性粒单核细胞白血病
图片尺寸1280x800
(图) 急性非淋巴细胞白血病m2a型骨髓象
图片尺寸1150x854
急性髓性白血病细胞
图片尺寸378x284白血病细胞
图片尺寸900x1200
外周血涂片#淋巴细胞白血病
图片尺寸676x1173
急性髓细胞白血病aml的m4e0型
图片尺寸1600x1200
急性髓细胞白血病aml的m4e0型
图片尺寸1600x1200
急性髓细胞白血病aml的m4e0型
图片尺寸1600x1200
细胞形态相似而本质不同的白血病两例---第六阶段第10期-a(总162期)
图片尺寸1280x800
英国赫尔约克医学院发现白血病细胞的遗传倾向
图片尺寸1024x767
猜你喜欢:白血病图片血液白血病图片骨髓白血病图片白血病细胞白血病图片早期白血病细胞分化白血病出血点图片单核白血病细胞白血病图片儿童细胞图片正常细胞图片白血病图片红点白血病红点图片工作细胞白细胞白血病血液细胞图片形态死亡细胞图片白血病死亡过程图片急性单核细胞白血病白血病血常规工作细胞图片细胞图片手绘图人体细胞图片白血病前兆皮肤图片白血病早期出血点图片植物细胞图片细胞图片卡通细胞图片线粒体白血病骨髓白血病早期嘴唇图片中年男士短发马增蕙简历唐诗咏春集梦薛小谦见女网友水雾魔珠海绵宝宝图案2021宝马325li曜夜无锡东站内部盖伊传说麦尔斯买袜子济南风景图片大全高清甜点图片 真实带一个宝字的图片霞浦油饼